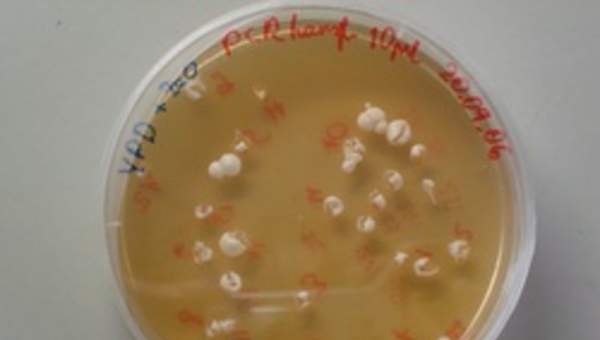
Levaduras en placa Levaduras en placa

36 horas pedagógicas
Unidad 3: Efectos del cigarrillo. Agentes infecciosos. Conductas saludables.
Efectos nocivos del cigarrillo y el contagio de enfermedades por agentes infecciosos. Promoción de conductas favorables para la salud.
Propósito
El objetivo central de la unidad es que los estudiantes tomen conciencia sobre los efectos nocivos para la salud que producen el consumo de cigarrillos y el contagio de enfermedades por agentes infecciosos. A partir de estos conocimientos, se espera que adopten conductas favorables para su salud. Al mismo tiempo, se pretende que reconozcan la existencia de agentes, como bacterias y hongos que son beneficiosas para la salud de las personas.
Para lograr estos propósitos, los alumnos deberán desarrollar las habilidades de formular preguntas significativas, planificar y llevar a cabo investigaciones de forma guiada, observar, predecir y comunicar los resultados. En este proceso, deberán medir y registrar información, representar datos en una variedad de formas, usar instrumentos de forma segura y utilizar la evidencia para respaldar sus ideas.
Conocimientos previos
- Actividad física y salud.
- Aporte de los alimentos.
- Sistema digestivo, respiratorio y circulatorio, en cuanto a estructuras y función.
Palabras claves
Cuerpo humano, cigarrillo, tabaco, agentes beneficiosos, agentes infecciosos, virus, bacterias, hongos, enfermedades, prevención, avances tecnológicos y salud.
Objetivos de la unidad
Indicadores
Indicadores Unidad 3
- Identifican las estructuras básicas que conforman el sistema respiratorio.
- Describen la función de los pulmones en el intercambio de gases.
- Identifican a la nariz y tráquea como conductos que poseen características que permiten proteger al organismo de enfermedades.
- Describen cómo la contracción y relajación del diafragma y algunas estructuras torácicas permiten la expansión y contracción de los pulmones.
- Explican mediante esquemas simples cómo se realiza el intercambio gaseoso.
- Relacionan los cambios de frecuencia respiratoria a las necesidades de oxigeno del cuerpo.
Indicadores
Indicadores Unidad 3
- Describen y analizan experiencias simples que evidencian los residuos producidos por el humo del tabaco.
- Explican que se producen daños graves a la salud en personas fumadoras y también en personas expuestas al humo del tabaco de forma pasiva.
- Identifican enfermedades del sistema respiratorio y circulatorio, provocadas por el consumo de tabaco (trombosis, arritmias, infecciones respiratorias, asma, cáncer pulmonar).
- Analizan las principales causas del consumo de tabaco en adolescentes, reconociendo el consumo de cigarrillos como una enfermedad adictiva.
- Comparan el consumo de cigarrillo en Chile respecto a países desarrollados.
Indicadores
Indicadores Unidad 3
- Describen el efecto beneficioso de algunas bacterias en el organismo (por ejemplo competencia con bacterias patógenas, evitando su colonización).
- Investigan los beneficios de algunos hongos comestibles.
- Identifican agentes dañinos para la salud (bacterias, virus y hongos).
- Describen cómo algunas enfermedades son producidas por el ingreso y multiplicación de agentes infecciosos en nuestro organismo.
- Distinguen las enfermedades producidas por agentes infecciosos (virus y bacterias), de otros tipos de enfermedades.
- Explican el uso de desinfectantes (ejemplo: cloro, alcohol, povidona yodada, agua oxigenada), como sustancias que eliminar gran parte de los agentes infecciosos y permiten prevenir enfermedades.
- Mencionan diversas acciones, como, lavarse las manos, cubrirse la boca al estornudar, lavar los alimentos, etc., que permiten prevenir el contagio de enfermedades infecto contagiosas.
Planificar y llevar a cabo investigaciones guiadas experimentales y no experimentales:
- sobre la base de una pregunta formulada por ellos u otros
- considerando el cambio de una sola variable
- trabajando de forma individual o colaborativa
- obteniendo información sobre el tema en estudio a partir de diversas fuentes y aplicando estrategias para organizar y comunicar la información.
Recursos de la unidad
Plan de lecciones CODE
Actividades evaluativas
Actividades complementarias
Actividades sugeridas
Libros de actividades
Imágenes
Presentaciones
Videos
Lecturas alumno
Libros BDE
Textos Escolares Licitados por Mineduc

Grupo: Título del recurso

Unidades
Unidad 1: El agua y los océanos
Características, distribución y estados del agua. Océanos, corrientes, efectos en el clima y la flora y fauna marina, mareas, actividades humanas relacionadas con el agua.
Unidad 2: Organización de los seres vivos. Sistemas del cuerpo humano.
Organización de los seres vivos, desde la célula hasta la totalidad del organismo. Importancia de la alimentación. Sistemas del cuerpo humano.
Unidad 3: Efectos del cigarrillo. Agentes infecciosos. Conductas saludables.
Efectos nocivos del cigarrillo y el contagio de enfermedades por agentes infecciosos. Promoción de conductas favorables para la salud.
Unidad 4: La electricidad. Formas de energía.
Estudio de los circuitos eléctricos. Conceptos de corriente y energía eléctrica. Diferentes formas de energía y su importancia.